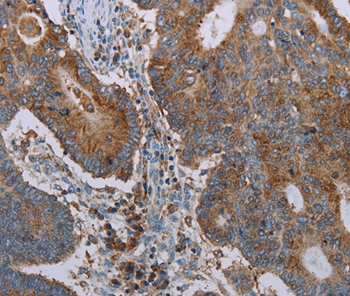

-
分类: 科研抗体货号: P42901别名: S9; Rpn6; p44.5应用: WB反应种属: Human,Mouse,Rat
-
分类: 科研抗体货号: P42924别名: EPG; PRO9904; ALGV3072应用: WB反应种属: Human,Mouse
-
分类: 科研抗体货号: P42941别名: CP7A; CYP7; CYPVII应用: IHC反应种属: Human
-
分类: 科研抗体货号: P42933别名: HAS应用: WB,IHC反应种属: Human,Mouse
-
分类: 科研抗体货号: P42923别名: PAC1; PAC-1应用: WB,IHC反应种属: Human,Mouse
-
分类: 科研抗体货号: P42940别名: pim-3应用: WB,IHC反应种属: Human,Mouse,Rat
-
分类: 科研抗体货号: P42931别名: CEPR; GPER; DRY12; FEG-1; GPR30; LERGU; LyGPR; CMKRL2; LERGU2; GPCR-Br应用: WB,IHC反应种属: Human
-
分类: 科研抗体货号: P42922别名: CRF1; CRHR; CRF-R; CRFR1; CRF-R1; CRFR-1; CRH-R1; CRHR1L; CRHR1f; CRF-R-1; CRH-R-1; CRH-R1h应用: IHC反应种属: Human
-
分类: 科研抗体货号: P42939别名: Trh1; LASS4应用: WB,IHC反应种属: Human
-
分类: 科研抗体货号: P42921别名: PIKE; GGAP2; CENTG1应用: WB,IHC反应种属: Human

鄂公网安备42018502007531号
鄂公网安备42018502007531号

